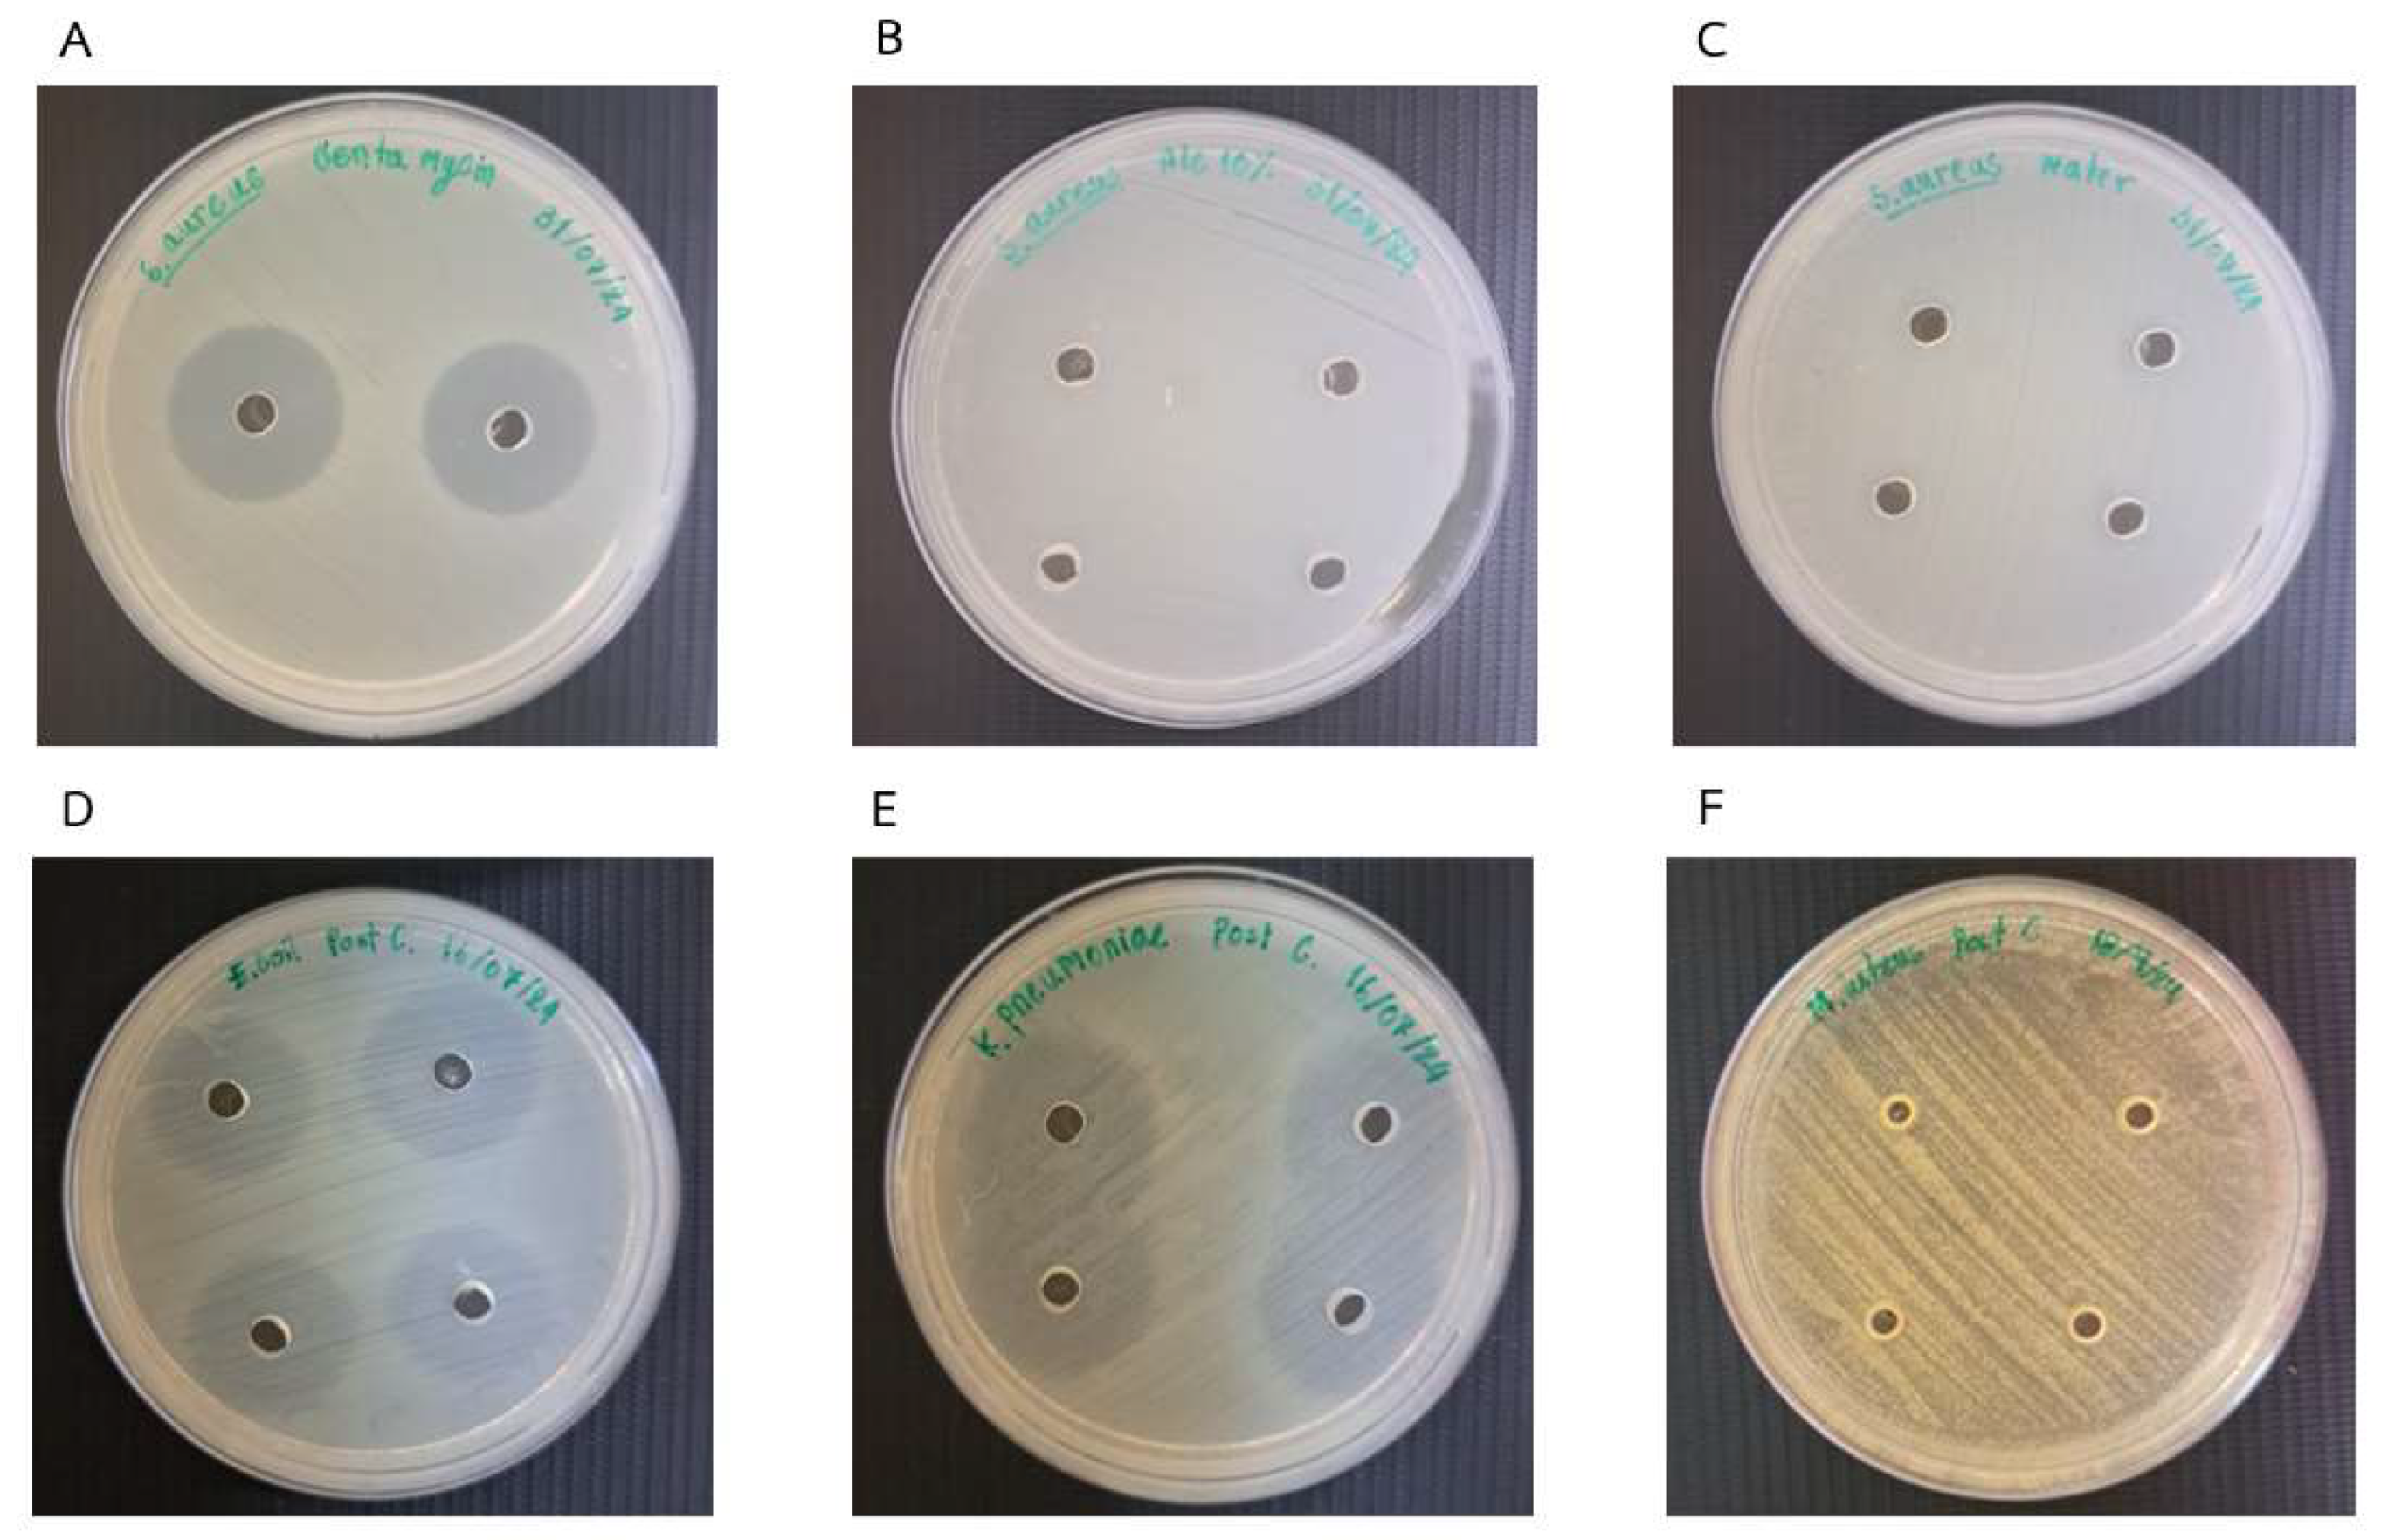
Fermentation 11 00190 g001

Comparative Analysis of Physicochemical and Biological Activities of Meads from Five Mekong Region Honeys Pre- and Post-Fermentation
Abstract
1. Introduction
2. Materials and Methods
2.1. Materials
2.2. Chemicals
2.3. Mead Fermentation
2.4. Color
2.5. pH
2.6. Sugar Content Analysis
2.7. Antimicrobial Activity
2.8. Determination of Antioxidant Activity Using 2,2-Diphenyl-1-picrylhydrazyl Free Radical Scavenging Assay
2.9. Total Phenolic Content
2.10. Total Flavonoid Content
2.11. Sensory Evaluation
2.12. Statistical Analysis
3. Results
3.1. Physicochemical Changes in Mead Before and After Fermentation
3.2. Antibacterial Activities
3.3. Antioxidant Activities
3.4. Total Phenolic and Flavonoid Contents
3.5. Sensory Evaluation
4. Discussion
5. Conclusions
Author Contributions
Funding
Institutional Review Board Statement
Informed Consent Statement
Data Availability Statement
Acknowledgments
Conflicts of Interest
References
- McGovern, P.E.; Zhang, J.; Tang, J.; Zhang, Z.; Hall, G.R.; Moreau, R.A.; Nunez, A.; Butrym, E.D.; Richards, M.P.; Wang, C.-S.; et al. Fermented beverages of pre- and proto-historic China. Proc. Natl. Acad. Sci. USA 2004, 101, 17593–17598. [Google Scholar] [PubMed]
- Xiang, H.; Sun-Waterhouse, D.; Waterhouse, G.I.; Cui, C.; Ruan, Z. Fermentation-enabled wellness foods: A fresh perspective. Food Sci. Hum. Wellness 2019, 8, 203–243. [Google Scholar]
- Liu, Y.; Jiang, B.; Wang, K. A review of fermented bee products: Sources, nutritional values, and health benefits. Food Res. Int. 2023, 174, 113506. [Google Scholar]
- Roldán, A.; van Muiswinkel, G.; Lasanta, C.; Palacios, V.; Caro, I. Influence of pollen addition on mead elaboration: Physicochemical and sensory characteristics. Food Chem. 2011, 126, 574–582. [Google Scholar]
- Yang, F.; Chen, C.; Ni, D.; Yang, Y.; Tian, J.; Li, Y.; Chen, S.; Ye, X.; Wang, L. Effects of Fermentation on Bioactivity and the Composition of Polyphenols Contained in Polyphenol-Rich Foods: A Review. Foods 2023, 12, 3315. [Google Scholar] [CrossRef]
- da Silva, P.M.; Gauche, C.; Gonzaga, L.V.; Costa, A.C.O.; Fett, R. Honey: Chemical composition, stability and authenticity. Food Chem. 2016, 196, 309–323. [Google Scholar] [CrossRef]
- Varela, C.; Pizarro, F.; Agosin, E. Biomass content governs fermentation rate in nitrogen-deficient wine musts. Appl. Environ. Microbiol. 2004, 70, 3392–3400. [Google Scholar]
- Bauer, F.F.; Pretorius, I.S. Yeast stress response and fermentation efficiency: How to survive the making of wine—A review. S. Afr. J. Enol. Vitic. 2019, 21, 27–51. [Google Scholar]
- AOAC. Official Methods of Analysis of AOAC International, 15th ed.; Association of Official Analytical Chemists: Arlington, VA, USA, 2000. [Google Scholar]
- Kamata, T.; Uemura, M. Solute accumulation in wheat seedlings during cold acclimation: Contribution to increased freezing tolerance. Cryo Lett. 2004, 25, 311–322. [Google Scholar]
- Hossain, M.L.; Lim, L.Y.; Hammer, K.; Hettiarachchi, D.; Locher, C. A Review of Commonly Used Methodologies for Assessing the Antibacterial Activity of Honey and Honey Products. Antibiotics 2022, 11, 975. [Google Scholar] [CrossRef]
- Kedare, S.B.; Singh, R.P. Genesis and development of DPPH method of antioxidant assay. J. Food Sci. Technol. 2011, 48, 412–422. [Google Scholar] [CrossRef] [PubMed]
- Chitarrini, G.; Debiasi, L.; Stuffer, M.; Ueberegger, E.; Zehetner, E.; Jaeger, H.; Robatscher, P.; Conterno, L. Volatile Profile of Mead Fermenting Blossom Honey and Honeydew Honey with or without Ribes nigrum. Molecules 2020, 25, 1818. [Google Scholar] [CrossRef] [PubMed]
- Shraim, A.M.; Ahmed, T.A.; Rahman, M.; Hijji, Y.M. Determination of total flavonoid content by aluminum chloride assay: A critical evaluation. LWT 2021, 150, 111932. [Google Scholar] [CrossRef]
- Stone, H.; Sidel, J.L. 6—Descriptive Analysis. In Sensory Evaluation Practices, 3rd ed.; Stone, H., Sidel, J.L., Eds.; Academic Press: San Diego, CA, USA, 2004; pp. 201–245. [Google Scholar]
- Mărgăoan, R.; Cornea-Cipcigan, M.; Topal, E.; Kösoğlu, M. Impact of Fermentation Processes on the Bioactive Profile and Health-Promoting Properties of Bee Bread, Mead and Honey Vinegar. Processes 2020, 8, 1081. [Google Scholar] [CrossRef]
- Gutiérrez-Escobar, R.; Aliaño-González, M.J.; Cantos-Villar, E. Wine Polyphenol Content and Its Influence on Wine Quality and Properties: A Review. Molecules 2021, 26, 718. [Google Scholar] [CrossRef]
- Ávila, F.; Schmeda-Hirschmann, G.; Silva, E. The Major Chromophore Arising from Glucose Degradation and Oxidative Stress Occurrence during Lens Proteins Glycation Induced by Glucose. Molecules 2018, 23, 6. [Google Scholar] [CrossRef]
- Abdul Hakim, B.N.; Xuan, N.J.; Oslan, S.N.H. A Comprehensive Review of Bioactive Compounds from Lactic Acid Bacteria: Potential Functions as Functional Food in Dietetics and the Food Industry. Foods 2023, 12, 2850. [Google Scholar] [CrossRef]
- Pereira, P.R.; Freitas, C.S.; Paschoalin, V.M.F. Saccharomyces cerevisiae biomass as a source of next-generation food preservatives: Evaluating potential proteins as a source of antimicrobial peptides. Compr. Rev. Food Sci. Food Saf. 2021, 20, 4450–4479. [Google Scholar] [CrossRef]
- Varela, C.; Torrea, D.; Schmidt, S.A.; Ancin-Azpilicueta, C.; Henschke, P.A. Effect of oxygen and lipid supplementation on the volatile composition of chemically defined medium and Chardonnay wine fermented with Saccharomyces cerevisiae. Food Chem. 2012, 135, 2863–2871. [Google Scholar] [CrossRef]
- Sen, O.; Hinks, J.; Lin, Q.; Lin, Q.; Kjelleberg, S.; Rice, S.A.; Seviour, T. Escherichia coli displays a conserved membrane proteomic response to a range of alcohols. Biotechnol. Biofuels Bioprod. 2023, 16, 147. [Google Scholar] [CrossRef]
- Fortes, J.P.; Franco, F.W.; Baranzelli, J.; Ugalde, G.A.; Ballus, C.A.; Rodrigues, E.; Mazutti, M.A.; Somacal, S.; Sautter, C.K. Enhancement of the Functional Properties of Mead Aged with Oak (Quercus) Chips at Different Toasting Levels. Molecules 2023, 28, 56. [Google Scholar]
- Adamenko, K.; Kawa-Rygielska, J.; Kucharska, A.Z.; Głowacki, A.; Piórecki, N. Changes in the Antioxidative Activity and the Content of Phenolics and Iridoids during Fermentation and Aging of Natural Fruit Meads. Biomolecules 2021, 11, 1113. [Google Scholar] [CrossRef] [PubMed]
- Socha, R.; Pająk, P.; Fortuna, T.; Buksa, K. Phenolic Profile and Antioxidant Activity of Polish Meads. Int. J. Food Prop. 2015, 18, 2713–2725. [Google Scholar]
- Akalın, H.; Bayram, M.; Anlı, R.E. Determination of some individual phenolic compounds and antioxidant capacity of mead produced from different types of honey: Properties of mead from different types of honey. J. Inst. Brew. 2017, 123, 167–174. [Google Scholar]
- Cheung, Y.; Meenu, M.; Yu, X.; Xu, B. Phenolic acids and flavonoids profiles of commercial honey from different floral sources and geographic sources. Int. J. Food Prop. 2019, 22, 290–308. [Google Scholar] [CrossRef]
- Bogdanov, S.; Jurendic, T.; Sieber, R.; Gallmann, P. Honey for Nutrition and Health: A Review. J. Am. Coll. Nutr. 2008, 27, 677–689. [Google Scholar]
- Balak, J.; Drábová, L.; Maťátková, O.; Doležal, M.; Marsík, D.; Kolouchova, I.J. Differences in Volatile Profiles and Sensory Characteristics in Plum Spirits on a Production Scale. Fermentation 2024, 10, 235. [Google Scholar] [CrossRef]
- Rezaei, A.; Alirezalu, K.; Damirchi, S.A.; Hesari, J.; Papademas, P.; Domínguez, R.; Lorenzo, J.M.; Yaghoubi, M. Effect of Pasteurization and Ripening Temperature on Chemical and Sensory Characteristics of Traditional Motal Cheese. Fermentation 2020, 6, 95. [Google Scholar] [CrossRef]
- Alfonzo, A.; Gaglio, R.; Barbera, M.; Francesca, N.; Moschetti, G.; Settanni, L. Evaluation of the Fermentation Dynamics of Commercial Baker’s Yeast in Presence of Pistachio Powder to Produce Lysine-Enriched Breads. Fermentation 2020, 6, 2. [Google Scholar]

| Samples | Color | pH | Glucose (mg/mL ± SD) | Fructose (mg/mL ± SD) | |
|---|---|---|---|---|---|
| Tree Marigold (T. diversifolia, Myanmar, M) | Pre | White | 3.78 ± 0.03 | 72.3 ± 0.5 | 86.4 ± 0.5 |
| Post | Extra white | 3.87 ± 0.03 | 0.03 ± 0.05 | 0.39 ± 0.18 | |
| Coffee (C. canephora, Vietnam, V) | Pre | White | 3.94 ± 0.04 | 58.4 ± 1.0 | 65.6 ± 0.9 |
| Post | Extra white | 3.94 ± 0.02 | 0.18 ± 0.07 | 0.40 ± 0.17 | |
| Kapok (C. pentandra, Cambodia, K) | Pre | Extra light amber | 3.65 ± 0.16 | 61 ± 3 | 117 ± 4 |
| Post | Extra light amber | 3.77 ± 0.05 | 0.7 ± 0.5 | 0.73 ± 0.11 | |
| Rubber (H. brasiliensis, China, C) | Pre | Extra white | 4.31 ± 0.02 | 88.8 ± 0.3 | 101.4 ± 0.6 |
| Post | Water white | 4.35 ± 0.04 | 0.13 ± 0.13 | 1.3 ± 0.5 | |
| Mixed Floral (Thailand, T) | Pre | White | 4.20 ± 0.02 | 75.7 ± 1.9 | 90.9 ± 1.9 |
| Post | Extra white | 4.19 ± 0.02 | 0.5 ± 0.4 | 1.2 ± 0.4 | |
| Sample | E. coli | K. pneumoniae | S. aureus | M. luteus | |
|---|---|---|---|---|---|
| Tree Marigold (T. diversifolia, Myanmar, M) | Pre | √ | - | - | - |
| Post | √ | √ | - | - | |
| Coffee (C. canephora, Vietnam, V) | Pre | √ | - | √ | - |
| Post | √ | √ | - | - | |
| Kapok (C. pentandra, Cambodia, K) | Pre | √ | - | - | - |
| Post | √ | √ | √ | - | |
| Rubber (H. brasiliensis, China, C) | Pre | √ | - | - | - |
| Post | √ | √ | - | - | |
| Mixed Floral (Thailand, T) | Pre | √ | - | - | - |
| Post | √ | √ | - | - | |
Disclaimer/Publisher’s Note: The statements, opinions and data contained in all publications are solely those of the individual author(s) and contributor(s) and not of MDPI and/or the editor(s). MDPI and/or the editor(s) disclaim responsibility for any injury to people or property resulting from any ideas, methods, instructions or products referred to in the content. |
© 2025 by the authors. Licensee MDPI, Basel, Switzerland. This article is an open access article distributed under the terms and conditions of the Creative Commons Attribution (CC BY) license (https://creativecommons.org/licenses/by/4.0/).
Share and Cite
Inwongwan, S.; Kitcharoen, T.; Wongsasuk, P.; Le Masurier, W.; Saksunwiriya, C.; Takioawong, P.; Pandith, H.; Intarasit, S.; Noirungsee, N.; Disayathanoowat, T. Comparative Analysis of Physicochemical and Biological Activities of Meads from Five Mekong Region Honeys Pre- and Post-Fermentation. Fermentation 2025, 11, 190. https://doi.org/10.3390/fermentation11040190
Inwongwan S, Kitcharoen T, Wongsasuk P, Le Masurier W, Saksunwiriya C, Takioawong P, Pandith H, Intarasit S, Noirungsee N, Disayathanoowat T. Comparative Analysis of Physicochemical and Biological Activities of Meads from Five Mekong Region Honeys Pre- and Post-Fermentation. Fermentation. 2025; 11(4):190. https://doi.org/10.3390/fermentation11040190
Chicago/Turabian StyleInwongwan, Sahutchai, Thanaporn Kitcharoen, Pitchayapak Wongsasuk, William Le Masurier, Chanon Saksunwiriya, Phuwasit Takioawong, Hataichanok Pandith, Sitthisak Intarasit, Nuttapol Noirungsee, and Terd Disayathanoowat. 2025. "Comparative Analysis of Physicochemical and Biological Activities of Meads from Five Mekong Region Honeys Pre- and Post-Fermentation" Fermentation 11, no. 4: 190. https://doi.org/10.3390/fermentation11040190
APA StyleInwongwan, S., Kitcharoen, T., Wongsasuk, P., Le Masurier, W., Saksunwiriya, C., Takioawong, P., Pandith, H., Intarasit, S., Noirungsee, N., & Disayathanoowat, T. (2025). Comparative Analysis of Physicochemical and Biological Activities of Meads from Five Mekong Region Honeys Pre- and Post-Fermentation. Fermentation, 11(4), 190. https://doi.org/10.3390/fermentation11040190

